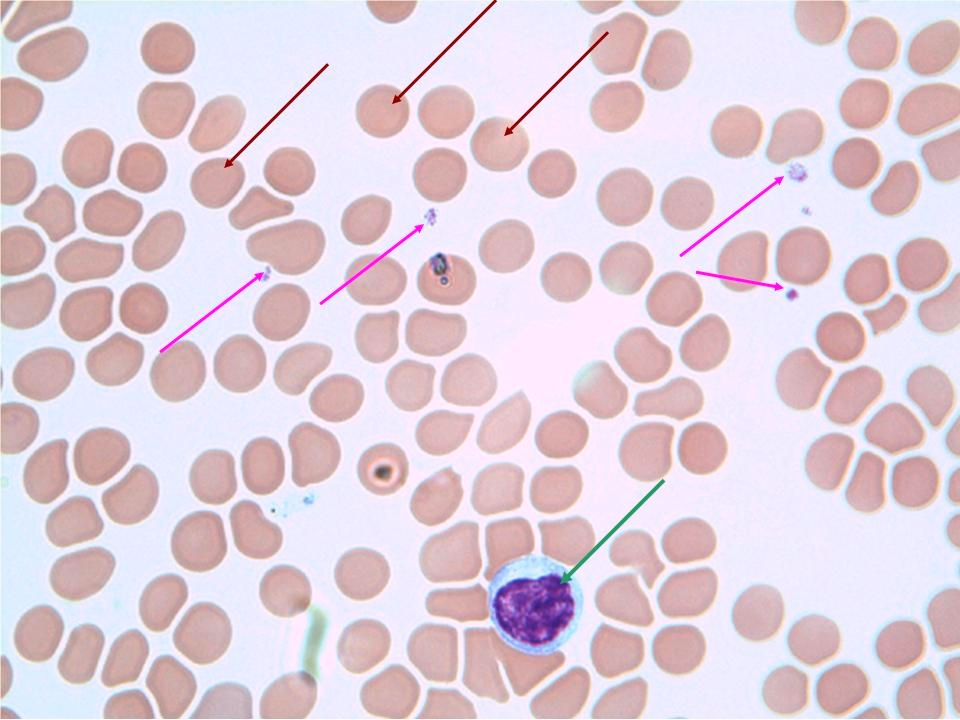
<p>Connective tissue: blood</p>

1/30
Looks like no tags are added yet.
Name | Mastery | Learn | Test | Matching | Spaced | Call with Kai |
|---|
No analytics yet
Send a link to your students to track their progress
What are the different types of Epithelial tissue?
Squamous
Cuboidal
Columnar
What are the different types of connective tissue?
Cartilage
Blood
Bone
What are the different types of muscle tissue?
Skeletal
Cardiac
Smooth
How are epitheliums distinguished by?
Simple and stratified
What is the difference between simple epithelium and stratified epithelium?
simple epithelium is only one cell layer thick
stratified epithelium is multiple cell layers thick

What type of tissue is this?
Epithelial tissue: simple squamous


What type of tissue is this?
Epithelial tissue: simple cuboidal


What type of tissue is this?
Epithelial tissue: Simple Columnar


What type of tissue is this?
Epithelial tissue: stratified squamous


What type of tissue is this?
Epithelial tissue: stratified cuboidal


What type of tissue is this?
Epithelial tissue: stratified Columnar


What type of tissue is this?
Connective tissue: blood

What type of tissue is this?
Connective tissue: Hyaline cartilage


What type of tissue is this?
Connective tissue: Bone


What type of tissue is this?
Muscle tissue: skeletal


What type of tissue is this?
Muscle tissue: cardiac


What type of tissue is this?
Muscle tissue: smooth


What type of tissue is this?
Nerve Tissue

What type of Epithelial tissue is this?
a single layer of thin, flat, scale-like cells with centrally located, flattened nuclei, designed for rapid diffusion, filtration, and osmosis
simple squamous
What type of Epithelial tissue is this?
a type of tissue composed of a single layer of cube-shaped cells with large, central, spherical nuclei
Simple Cuboidal
What type of Epithelial tissue is this?
a single layer of tall, narrow cells with basally located, oval nuclei, specialized for high-level absorption and secretion
Simple Columnar
What type of Epithelial tissue is this?
consists of multiple layers of cells, with flattened squamous cells at the surface and cuboidal/columnar cells at the basal layer, specialized for protection against abrasion, pathogens, and dehydration
stratified squamous
What type of Epithelial tissue is this?
a rare, multi-layered tissue composed of cube-shaped cells, with apical layers being specifically cuboidal
stratified cuboidal
What type of Epithelial tissue is this?
a rare, protective, and secretory tissue characterized by multiple cell layers, with the topmost layer consisting of column-shaped cells, while deeper layers are smaller and more cuboidal
stratified Columnar
What type of Connective tissue is this?
liquid matrix and can flow
Blood
What type of Connective tissue is this?
rubbery/gelatinous matrix, the tissue keeps its shape, but can be stretched or twisted
Hyaline Cartilage
What type of Connective tissue is this?
hard, solid matrix of calcium minerals
Bone
What type of Muscle tissue is this?
voluntary, i.e., activated by a conscious command or by reflex.
Skeletal
What type of Muscle tissue is this?
a specialized, involuntary, striated muscle tissue found only in the heart, responsible for its rhythmic contractions that pump blood throughout the body
Cardiac
What type of Muscle tissue is this?
an involuntary, non-striated tissue composed of spindle-shaped, uninucleated cells
Smooth
What are the layers of skin called?
Epidermis
Dermis
Superficial fascia